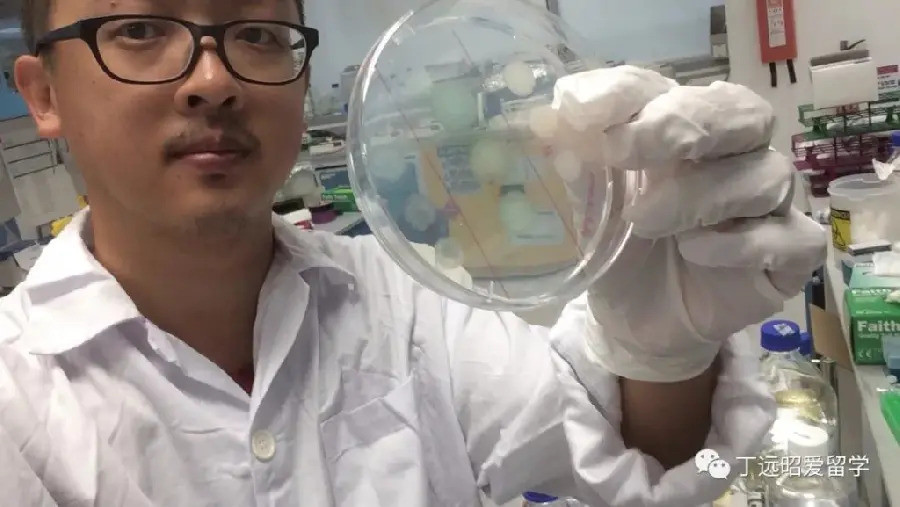

-
Hà Nội: 2 nam sinh cấp cứu vì trò đùa của bạn với chìa khóa cắm đầu, bút cắm vào nơi nhạy cảm -
Vé máy bay Hà Nội – TP.HCM bất ngờ giảm mạnh sát lễ 30/4, giá hiện tại khiến nhiều người ngỡ ngàng -
Xôn xao tấm thiệp mời dự "lễ cúng tạ từ cõi chết trở về", chủ nhân nói gì? -
Chồng chi 15 triệu tạo bất ngờ nghỉ lễ 30/4, vợ không kịp "ồ" lên đã thấy nghẹn lòng -
Lý do Bộ Công Thương loại dầu hỏa khỏi danh mục giá cơ sở, cơ chế điều hành giá xăng dầu từ 29/4 có thay đổi gì? -
Cú sốc 2 tỷ USD: Trung Quốc chính thức dập tắt tham vọng thâu tóm Manus AI của Meta -
Nguồn cơn vụ người đàn ông nước ngoài lao vào đá ô tô, tát tài xế ở Đà Nẵng khiến CĐM bức xúc -
Bộ Công an kết luận: Dự án “Nuôi em”, “Sức mạnh 2000” không có dấu hiệu tội phạm -
Đậu đen: "Thực phẩm vàng" giải nhiệt và hỗ trợ đẩy lùi 4 bệnh mãn tính -
Nhiều doanh nghiệp "lao đao" vì đầu tư cổ phiếu, phải trích lập dự phòng hàng chục tỷ đồng
Thế giới
30/06/2025 17:29Shipper U40 có bằng thạc sĩ, tiến sĩ từ các trường danh giá, gây sốt mạng
Theo World Journal, chàng trai đặc biệt này là Ding Yuanzhao, sinh ra và lớn lên ở Trung Quốc. Ngay từ khi còn bé, Ding đã luôn khiến cha mẹ và gia đình tự hào nhờ thành tích học tập ấn tượng.



Năm 2004, anh là thủ khoa đầu vào của Đại học Thanh Hoa. Ding tiếp tục nối dài sự nghiệp học vấn trong những năm tiếp theo bằng việc lấy bằng thạc sĩ kỹ thuật năng lượng tại Đại học Bắc Kinh (Trung Quốc) cũng như thạc sĩ đa dạng sinh học từ Đại học Oxford (Anh).
Chưa hết, chàng trai sinh năm 1986 này còn có bằng tiến sĩ sinh học tại Đại học Công nghệ Nanyang (Singapore) và cũng đã hoàn thành một dự án nghiên cứu sau tiến sĩ tại Đại học Quốc gia Singapore.
Đây hầu hết đều là các trường thuộc top 30 đại học hàng đầu thế giới.
Bước ngoặt cuộc đời của Ding Yuanzhao đến vào tháng 3/2024, khi hợp đồng nghiên cứu của anh không được gia hạn. Dù nỗ lực tìm kiếm công việc phù hợp với năng lực, Ding liên tiếp bị từ chối và rơi vào cảnh thất nghiệp nơi đất khách quê người.
Trong cơn tuyệt vọng cũng như để duy trì cuộc sống, Ding xin làm nhân viên giao đồ ăn tạm thời. Theo lời kể của chàng trai, anh phải làm việc 11 đến 12 tiếng mỗi ngày, bất kể mưa hay nắng và kiếm được trung bình 50-100 đô la Singapore (1-2 triệu đồng)/ngày, riêng Chủ nhật sẽ kiếm được khoảng 254 đô la Singapore (5,2 triệu đồng).
Nhân kỳ thi tuyển sinh vào đại học ở Trung Quốc, Ding quyết định chia sẻ câu chuyện của bản thân lên mạng xã hội như một cách tiếp thêm động lực cho các sĩ tử trong nước.

Theo Ding, ở Singapore, nhà tuyển dụng thường ưu tiên năng lực cá nhân hơn bằng cấp. Bên cạnh đó, trong bối cảnh siết chặt chính sách với lao động nước ngoài, việc các công ty ưu tiên người bản địa khiến cơ hội cho những người như anh càng hạn chế. Chưa kể, chuyên ngành sinh học mà anh theo đuổi vốn đã khan hiếm việc làm, lại đi kèm những yêu cầu tuyển dụng khắt khe.
Theo anh, nghề giao hàng tuy giản dị nhưng vẫn đủ để nuôi sống gia đình và đóng góp cho xã hội, miễn là làm việc một cách nghiêm túc. Anh cũng nhắn nhủ mọi người hãy luôn trân trọng và tự hào với công việc mình đang làm, dù đó là công việc gì.
"Chỉ khi tự nuôi được bản thân, tôi mới có thể chủ động tìm hướng đi mới", Ding nói.
Ngay sau khi đăng tải, câu chuyện của Ding Yuanzhao trở thành đề tài bàn tán trên mạng xã hội. Nhiều người cho rằng với bằng cấp như vậy, Ding có thể dễ dàng đi dạy hoặc làm gia sư. Nhưng anh phản bác rằng không phải cứ học giỏi là dạy giỏi.
Hiện nay, không ít sinh viên mới ra trường ở nhiều quốc gia châu Á như Trung Quốc, Singapore, Việt Nam,... cũng chọn làm nghề giao hàng như một cách cầm cự trong thời kỳ việc làm khó khăn.
Theo báo cáo năm 2024 của nền tảng tuyển dụng Zhaopin, tỷ lệ người giao hàng ở Trung Quốc có bằng cao đẳng trở lên là 38%, tăng 12% so với 2 năm trước.
Theo Đỗ An (VietNamNet)
- Hà Nội: 2 nam sinh cấp cứu vì trò đùa của bạn với chìa khóa cắm đầu, bút cắm vào nơi nhạy cảm (15:15)
- Xử phúc thẩm nhóm cán bộ tòa án Đà Nẵng nhận hối lộ: Cựu Phó chánh án bất ngờ nhận tội, xin hưởng án treo (15:12)
- Vé máy bay Hà Nội – TP.HCM bất ngờ giảm mạnh sát lễ 30/4, giá hiện tại khiến nhiều người ngỡ ngàng (15:08)
- Hai cựu Thủ tướng Israel lập "siêu liên minh" quyết hạ bệ ông Netanyahu (15:06)
- Thảm kịch ngày sinh nhật: Bé trai 7 tuổi tử vong thương tâm do bị kẹt trong ống hút bể bơi (31 phút trước)
- Xôn xao tấm thiệp mời dự "lễ cúng tạ từ cõi chết trở về", chủ nhân nói gì? (55 phút trước)
- HLV Michael Carrick: MU không nên vội mừng với tấm vé Champions League sớm (59 phút trước)
- Động thái bất ngờ của "cô dâu 35 tỷ" và chồng thiếu gia sau tuyên bố đường ai nấy đi (1 giờ trước)
- Người nghiện cà phê lâu năm: Những hệ lụy âm thầm ít người nhận ra (1 giờ trước)
- Chồng chi 15 triệu tạo bất ngờ nghỉ lễ 30/4, vợ không kịp "ồ" lên đã thấy nghẹn lòng (1 giờ trước)